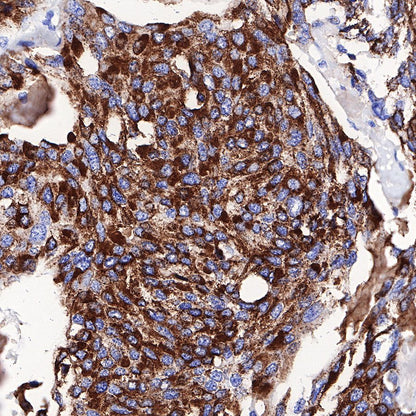
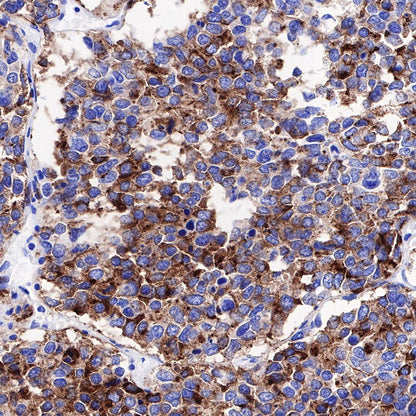

Product Specification
| Host |
Rabbit |
| Antigen |
Chromogranin A |
| Synonyms |
CgA, Pituitary secretory protein I, SP-I |
| Immunogen |
Synthetic Peptide |
| Location |
Secreted |
| Accession |
P10645 |
| Clone Number |
SDT-074-57 |
| Antibody Type |
Recombinant mAb |
| Application |
WB, IHC-P, IP |
| Reactivity |
Hu, Ms, Rt |
| Predicted Reactivity |
Bv, Pg |
| Purification |
Protein A |
| Concentration |
0.25 mg/ml |
| Tag |
N/A |
| Physical Appearance |
Liquid |
| Storage Buffer |
PBS, 40% Glycerol, 0.05% BSA, 0.03% Proclin 300 |
| Stability & Storage |
12 months from date of receipt / reconstitution, -20 °C as supplied |
Dilution
| application |
dilution |
species |
| WB |
1:500 |
|
| IHC-P |
1:1000-1:2000 |
|
| IP |
1:25 |
|
Background
Chromogranin A (CgA) is a prohormone and granulogenic factor in endocrine and neuroendocrine tissues, as well as in neurons, and has a regulated secretory pathway [PMID: 28228748]. Chromogranin A is known as an important marker of neuroendocrine tumors [PMID: 24325234]. The intracellular functions of CgA include the initiation and regulation of dense-core granule biogenesis and sequestration of hormones in neuroendocrine cells. This protein is co-stored and co-released with secreted hormones. The extracellular functions of CgA include the generation of bioactive peptides, such as pancreastatin (PST), vasostatin, WE14, catestatin (CST), and serpinin [PMID: 28228748].